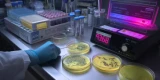

Recombinant protein production
Recombinant proteins are engineered proteins produced by genetically modified cells and play a vital role in therapeutics, diagnostics, and research due to their specificity and scalability. Examples of cell lines commonly used to produce recombinant proteins include CHO (Chinese Hamster Ovary), HEK293, Vero, and Sf9 cells, among others. Traditional single-use technologies like depth filters and centrifuges often face challenges with high-density cultures and large batch volumes. The FUNDALOOP® single-use filter enables efficient clarification through cyclical cake filtration, delivering excellent product recovery, high filtrate clarity, and reduced filter area requirements. Its fully enclosed, disposable design minimizes contamination risk, while heel volume filtration and back-flush steps increase yield and reduce waste. Scalable from lab to production scale, the FUNDALOOP® offers a robust alternative to traditional cell harvest methods.